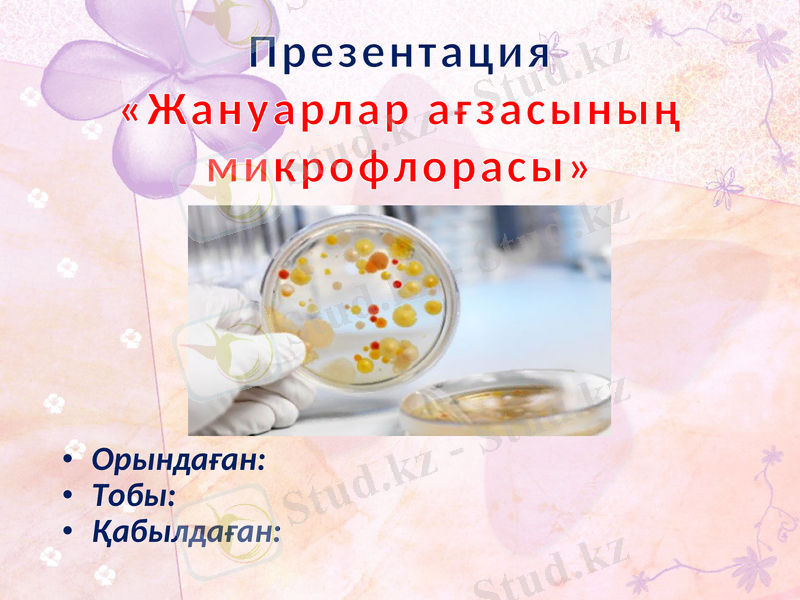
Slide 1

Жануар ағзасының қалыпты микрофлорасы: құрылымы, физиологиялық қызметтері және гнотобиология

Презентация «Жануарлар ағзасының микрофлорасы»
Орындаған:
Тобы:
Қабылдаған:

Жоспар
1. Кіріспе
2. Негізгі бөлім
2. 1. Қалыпты микрофлора
2. 2. Терінің және оның жүн түгінің құрылымы
2. 3. Ауыз қуысының микрофлорасы
2. 4. Асқазан-ішек трактысының микрофлорасы
2. 5. Ішек микрофлорасының микроорганизмдері
2. 6. Қалыпты микрофлораның физиологиялық қызметтері
2. 7. Микрофлорасыз өмір сүретін жануарлар
2. 8. Гнотобиология
3. Қорытынды
Қолданылған әдебиеттер тізімі

Кіріспе
Микрофлора (микро және флора) - белгілі бір ортада кездесетін микроорганизмдер жиынтығы. Олардың қатарында белгілі бір экологиялық факторға сәйкес, сол жерде тіршілік ететін жануарлар мен өсімдіктерге тән әр түрлі түрге жататын микроорганизмдер де бар. Табиғи жағдайда әр түрлі микроорганизмдер: бактериялар, актиномицеттер, микроскоппен көрінетін саңырауқұлақтар, балдырлар белгілі бір ортада тіршілік етеді. Солардың ішінде Жер шарының кез келген жерінде кездесетін топырақ Микрофлорасы. Олар топырақ құрылымын түзуде үлкен рөл атқарады. Топырақтың 1 граммында 10 миллионнан бірнеше миллиардқа дейін Микрофлоралар кездеседі. 3 - 5 га топырақта 3 - 5 т Микрофлора биомассасы жиналады. Микрофлораның ең көп таралған жері - су. Олардың мұндағы мөлшері әр түрлі факторларға байланысты өзгеріп отырады. Осыған байланысты судың Микрофлорасын бірнеше аймақтарға бөліп зерттейді (полисапрофты, мезасапрофты, т. б. ) . Микрофлоралардың тағы бір шоғырланған жері адам мен жануарлар денесі. Мысысалы, олар теріде, тыныс жолдарында, ауыз қуысында, күйіс қайтаратын малдардың таз қарынында да кездеседі. Олар қарын ішіндегі клетчатканы қантқа дейін ыдыратады. Сонымен бірге асқазан, ішектерде тіршілік етіп, ас қорытуға зиянын тигізбейтін Микрофлоралар да бар.

Қалыпты микрофлора
Қалыпты микрофлора деп - дені сау индивидтердің белгілі бір денесінің аймақтарында қалыпты мөлшерде жиі кездесетін микроорганизмдердің жиынтығы.
Белгілі бір түрге тән микрофлора индигенді деп аталады. Оның біршама тұрақты бөлімін «облигатты», «факультативті» деп ажыратады.
Жануарлардың микрофлорасы эволюциялық процесс кезінде микрофлора мен макроорганизмнің өзара байланысы нәтижесінде түзіледі. Ағзаның әр облысы үшін бел-гілі бір микрофлора тән. Жаңадан туылған ағза стерильді, ал 6-10 сағаттан кейін оның ағзасынан бір қатар микробтар табуға болады.

Терінің және оның жүн түгінің құрылымы
Терінің атқаратын қызметі жануарлар организмін сыртқы ортадан, механикалық химиялық және бактериялық әсерлерден қорғайды, жылу алмасуды реттейді сезіну органдары болып, сонымен қатар жануардың тіршілігіндегі өңделген заттарды денеден бөліп шығару қызметін атқарады.
Тері қасиеттері, организмнің сыртқы орта әсеріне сәйкестенудің және оның тері құрылымының ерекшеліктерінің әсерінің жоғарғы үлгісі ретінде қызмет ете алады. Жануарлардың өмір сүру жағдайына, климаттық факторларға, жыл мезгілдеріне байланысты теріде, өнімнің тауарлық құндылығына және өңдеу тәсілдеріне әсер ететін айтарлықтай өзгерістер болып тұрады.
Жануарлар тері құрылымы, өзінің жоғарғы сапасына және қысқы жағдайына байланысты, сонан соң мезгілдік өзгеріс ерекшеліктері тұрғысынан, қарастырылады.

Тері тканінің құрылымы
Жануарлар терісінің ткані жүн астында жұқа беткі қабатқа - қыртысқа және негізін құрайтын өзеңге бөлінеді. қыртыс жекеленген клеткалардан ал өзең күрделі шиленіскен талшықтардан тұрады.
Өзеңнің жануарлар денесіне беттесетін төменгі жағында өзең талшығы арқылы жұқа бұлшықтық ткандер мен майлы қабаттар орналасқан.
Теріде май және тері бездері, қан тамырлары, май клеткалары, нерв талшықтары болады.
а- қыртыс; б - өзеңнің емізекше қабаты;
в - өзеңнің торлы қабаты;
г - тері асты майлы қабаты;
1 - түк(стержень волоса) ;
2 - тері бездерінің шығу жолдары; 3 - май бездері;
4 - түк қалташасы; 5 - жүнді тікірейтетін бұлшықтар;
6 - тері бездері; 7 - коллаген талшықтар тобы.

Ауыз қуысының микрофлорасы
Ауыз қуысы көптеген микроорганизмдердің негізгі кіретін жолы негіздік реакция, тамақ қалдықтары және термостатта температура, осының бәрі олардың дамуына ықпал жасайды. Көптеп кездесетіндері: стрептококктар, стафилококктар, нейссериялар, вейлонеллалар, фу-зобактериялар, бактероидтар, лактобацилдер, спириллалар, вибриондар және дрожждар.

Асқазан-ішек трактысының микрофлорасы
Көптеген зерттеушілердің айтуынша жануарлардың асқазан микрофлорасы болмайды немесе өте аз мөлшерде кездеседі. Асқазанның микробсыз жағдайда болуының себебі, асқазан сөлі мен бактерицидті заттардың әсері деп түсіндіреді.
Ащы ішек пен тоқ ішектің «стерильді» немесе микроб жайлағаны жөнінде толық жауап жоқ.
Қолдағы анықтамалар бойынша, 12-елі ішекте микрофлора болмайды немесе онда кейбір сапрофиттер болуы мүмкін: энтерококктар мен лактобацилдер, біршама саңырауқұлақтар мен сарциналар.
Ащы ішектің дистальді бөлігінде микрофлора саны көбейе береді және оның спектрі де әртүрлі болады. Көптеген анаэробтар, ішекті және сүт қышқылы таяқшалары мен фекальді стрептококктар мен энтерококктар.
Әсіресе тоқ ішек пен үлкен дәрет микрофлораға өте бай және алуан түрлі. Жануардың тоқ ішегінде орта есеппен 1, 5 кг микроорганизмдер, ал 1г үлкен дәретте 250 млрд микроорга-низмдер бар екендігіесептелінеді.

Ішек микрофлорасының микроорганизмдері
Ішек микрофлорасының микроорганизмдері 8-10 түрлі туыстар мен 60 шақты түрлер мен туыстарға жатады.
Облигатты ішек флорасына жататындарға: бифидобактериилер, бактероидтар, лактобакте-риилер, ішек таяқшалары мен энтерококктар жатады.
Бифидобактериилер жас нәрестенің тоқ ішегіндегі ана сутімен қоректенетін негізгі фло-расы болып есептелінеді. Отандық ғалымдардың жұмысы, олардың адамдардың ағзасында доминатты мөлшерде кездесетінін анықтап көрсетті.
Факультативті ішек флорасының тобына патогенді және шартты-патогенді бактерия түр-лері мен сапрофиттер жатады.
Жасанды тамақтануға ауысқандар аэробты флора мөлшері көбейіп, спектірі кеңейеді және белгілі мөлшерде биохимиялық активтілігі өзгереді. Бұл рН-тың өлшемі мен фекалиидің тотығу-тотықсыдану потенциалында айқындалады. Нәтижесінде фекальді флора, үлкен жануардың флорасына ұқсас болып келеді. Ағзаның қартаюы, сүт қышқылы микробтарының азаюы мен ішек флорасының ферментативті жіберуімен гемолитикалық штамдардың пайда болуымен және кейбір микроорганизмдердің агрессия факторларымен қатар жүреді.

Қалыпты микрофлораның физиологиялық қызметтері
Қалыпты микрофлораның жануар ағзасы үшін пайдалылығы қазіргі уақытта үлкен сенімділікпен дәлелденіп отыр. Қалыпты микрофлораның микроорганизмді инфек-цияданқорғаушы фактор және сол қалыпты флораны реттеуші фактор екендігі, қалыпты флораның антоганистік қасиеті белгілі.
Ішек флорасы:
1. асқорыту процесінде үлкен роль атқарып, ішектің тегіс мускулатурасының тонусын көбейтеді.
2. Ағзада витаминдік қажеттіліктің үлкен бөлігін қамтамассыз етеді. Микроорганизм 9-дан аса В комплексіне жататын витаминдерді, никотин және фоли қышқылы, витамин К және басқа да витаминдерді синтездеуге қабілетті.
3. Ағзада ортақ иммунитеттің қалыптасуына үлкен қызмет атқарады. Оның болмауы клет-калық және гуморальдық иммунитеттерді әлсіреуіне әкеліп соғады. Мысалы: жақында алынған зерттеулерге қарағанда қан сарысуының синтезі қалыпты микрофлораға байла-нысты.

Микрофлорасыз өмір сүретін жануарлар
Көптеген жануарларды зерттеу нәтижесінде микрофлорасыз жануарлардың ерекше жағдайда өмір сүре алатындығы дәлелденді. Бірақ бұл табиғи ортада жануарлардың микро-флорамен симбиотикалық байланысының қажеті жоқ дегенді білдірмейді, нақты гнотобио-логия ағзада ішек бактерияларының негізгі маңызының нақты дәлелдерін ұсынады.
Қазіргі жаңа саладғы гнотобионттар қалыпты микрофлораның тікелей немесе жанама әсер ететін процестерін зерттеу үшін қолданады.
Қалыпты микрофлораның жануар ағзасының өмір сүру барысындағы негізгі ролін неғұрлым шынайы дәлелдемелерін, тек қана салыстырмалы түрде микробсыз, гноторофты және кәдімгі жануарларданалуға болады.
Микробсыз жануарларды арнайы аппарат - изоляторда өсіреді.

Қалыпты микрофлораның жануардың әртүрлі ауруларының этиологиялық факторы
Жануар ағзасына әртүрлі қолайсыз факторлардың әсер етуінен микрофлораның өзгеруі мүмкін. Мысалы: (рационсыз антибиотиктерді қолдану)
1. облигатты өкілдердің концентрациясының өзгеруі
2. факультативті микробтардың концентрациясының өзгеріп, оның көбеюі.
3. болуы мүмкін емес жерлерде микроорганизмдердің пайда болуы.

Гнотобиология
Гнотобиология - медицина мен биологияның қосылған жері. Бұл жер қалыпты микро-флораның жануарлар мен адам ағзасында физиологиялық және патологиялық жағдайдағы маңызын зерттейді.
Гнотобиологияны зерттеуге негізгі «гнотобионттар» деп аталған екі түрлі категориялы жануарлар болып табылады.
1. Стерильді изоляция жағдайында өсірілген микробсыз немесе микробиологиялық сте-рильді жануарлар.
2. Гнотофорлар - бір немесе бірнеше түрлі идентифицирленген микроорганизмі бар жану-арлар.
Гнотофордың құрамындағы микробтардың түрінің санына байланысты ағзада мекендейтін гнотофорларды моно-, ди-, три-, полигнотофорлы деп атайды.
- Іс жүргізу
- Автоматтандыру, Техника
- Алғашқы әскери дайындық
- Астрономия
- Ауыл шаруашылығы
- Банк ісі
- Бизнесті бағалау
- Биология
- Бухгалтерлік іс
- Валеология
- Ветеринария
- География
- Геология, Геофизика, Геодезия
- Дін
- Ет, сүт, шарап өнімдері
- Жалпы тарих
- Жер кадастрі, Жылжымайтын мүлік
- Журналистика
- Информатика
- Кеден ісі
- Маркетинг
- Математика, Геометрия
- Медицина
- Мемлекеттік басқару
- Менеджмент
- Мұнай, Газ
- Мұрағат ісі
- Мәдениеттану
- ОБЖ (Основы безопасности жизнедеятельности)
- Педагогика
- Полиграфия
- Психология
- Салық
- Саясаттану
- Сақтандыру
- Сертификаттау, стандарттау
- Социология, Демография
- Спорт
- Статистика
- Тілтану, Филология
- Тарихи тұлғалар
- Тау-кен ісі
- Транспорт
- Туризм
- Физика
- Философия
- Халықаралық қатынастар
- Химия
- Экология, Қоршаған ортаны қорғау
- Экономика
- Экономикалық география
- Электротехника
- Қазақстан тарихы
- Қаржы
- Құрылыс
- Құқық, Криминалистика
- Әдебиет
- Өнер, музыка
- Өнеркәсіп, Өндіріс
Қазақ тілінде жазылған рефераттар, курстық жұмыстар, дипломдық жұмыстар бойынша біздің қор #1 болып табылады.



Ақпарат
Қосымша
Email: info@stud.kz